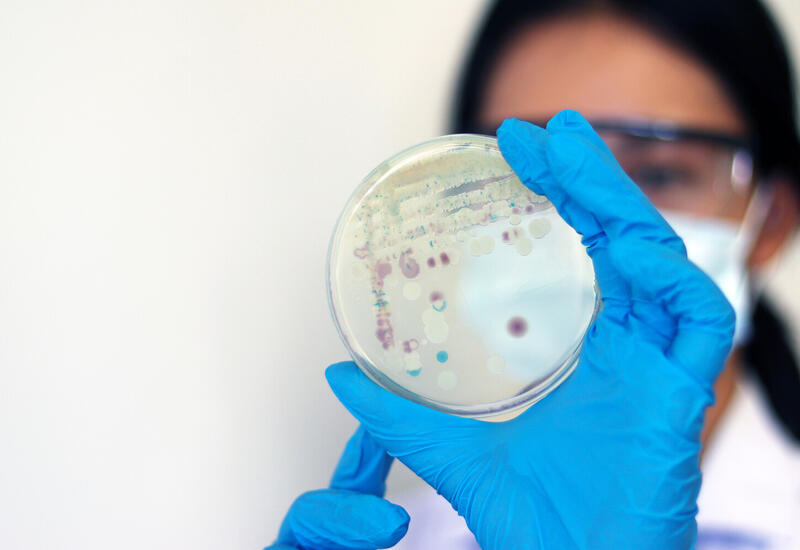

Учёные нашли неожиданное применение плесени
Исследователи из Университета Юты обнаружили, что почвенный плесневый гриб Marquandomyces marquandii способен образовывать уникальный гидрогель, который потенциально может заменить мягкие ткани человека.
Как передает Day.Az, результаты исследования опубликованы в The Journal of The Minerals, Metals & Materials Society (JMMMS).
Гидрогели уже давно привлекают внимание медиков и инженеров - эти материалы удерживают влагу, обладают мягкостью и эластичностью, напоминающей кожу, хрящи и мышцы. Но до сих пор синтетические аналоги были либо слишком хрупкими, либо плохо взаимодействовали с живыми клетками.
По словам ученых, M. marquandii в лабораторных исследованиях продемонстрировал неожиданные свойства. При выращивании в жидкой питательной среде он создает многослойную волокнистую структуру, удерживающую до 83% воды.
"Такие слои имеют разную пористость - от 40% до 90%, что важно для имитации различных типов тканей. То, что мы видим, - это гидрогель, который буквально растет сам по себе", - объясняет один из авторов работы, материаловед Атул Агравал.
Исследователи объяснили: секрет кроется в мицелии - подземной "корневой" системе грибов. Он состоит из нитей, способных бесконечно расти при наличии питательных веществ, формируя прочную, но гибкую структуру. К тому же он богат хитином - веществом, близким по составу к панцирям ракообразных, которое уже давно признано биосовместимым.
Исследователи надеются, что в будущем такой материал можно будет использовать как основу для выращивания клеток, создания имплантов или даже носимых биоустройств.
Говорить о применении "грибной кожи" для лечения ожогов или создания протезов пока рано, однако ученые намерены продолжить исследования. Команда планирует выяснить, насколько безопасен гриб для человека - есть вероятность, что содержащийся в нем хитин может вызывать редкие аллергии.
Заметили ошибку в тексте? Выберите текст и сообщите нам, нажав Ctrl + Enter на клавиатуре



